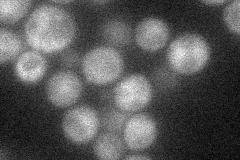
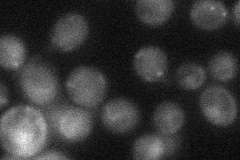
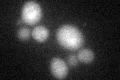

View description
Transcription factor that stimulates expression of proteasome genes; Rpn4p levels are in turn regulated by the 26S proteasome in a negative feedback control mechanism; RPN4 is transcriptionally regulated by various stress responses
Localization:
Intensity:
Fold change:
Significance:
-
C’ GFP library in SD

nucleus21.1 -
N' NOP1pr-GFP in SD
cytosol,nucleus29.2761 -
N' TEF2pr-mCherry in SD

below threshold5.66054 -
N' NATIVEpr-GFP in SD
punctate,nucleus29.485 -
N' TEF2pr-VC and Cyto-VN in SD

#N/A0 -
C’ GFP library in SD+DTT
nucleus19.520.92No -
C’ GFP library in SD+H2O2

nucleus28.811.36Yes -
C’ GFP library in Starvation Media

nucleus16.940.8Yes -
C’ GFP library on the background of Pup2-DaMP

nucleus -
C’ GFP library on the background of CCT mutant

nucleus23.67921.12178No
